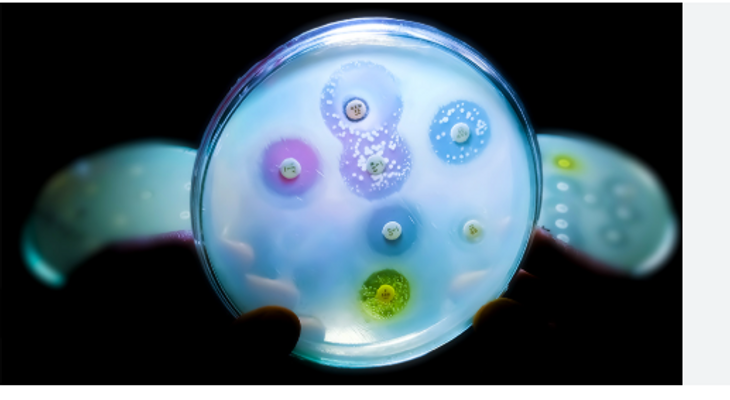

APUNTE.COM.DO, SANTO DOMINGO. -Una nueva cepa de bacteria altamente resistente a los antibióticos está generando preocupación en hospitales de Europa, Asia y América.
La expansión rápida y la baja respuesta a los tratamientos habituales mantienen en alerta a las autoridades sanitarias.
La OMS, dirigida por el Dr. Tedros Adhanom Ghebreyesus, ha reiterado que la resistencia antimicrobiana es una de las mayores amenazas de este siglo.
La epidemióloga Dra. Maria Van Kerkhove también ha advertido sobre el avance constante de bacterias capaces de evadir medicamentos esenciales.
Los CDC, bajo la dirección de la Dra. Mandy Cohen, afirman que el aumento de infecciones resistentes ya se refleja en varios sistemas hospitalarios del mundo.
En América Latina, países como Chile, México y República Dominicana reforzaron los protocolos de vigilancia y aislamiento en centros médicos.
La OPS, encabezada por el Dr. Jarbas Barbosa, llamó a frenar el uso indiscriminado de antibióticos, tanto en humanos como en animales.
Expertos insisten en que la automedicación sigue siendo uno de los principales factores que empujan la creación de bacterias resistentes.
El periodista y abogado Ramiro Estrella, director de Apunte.com.do, señaló que “la resistencia antimicrobiana es un enemigo silencioso que crece sin hacer ruido”.
Las autoridades recomiendan completar los tratamientos recetados y acudir al médico ante cualquier infección persistente.